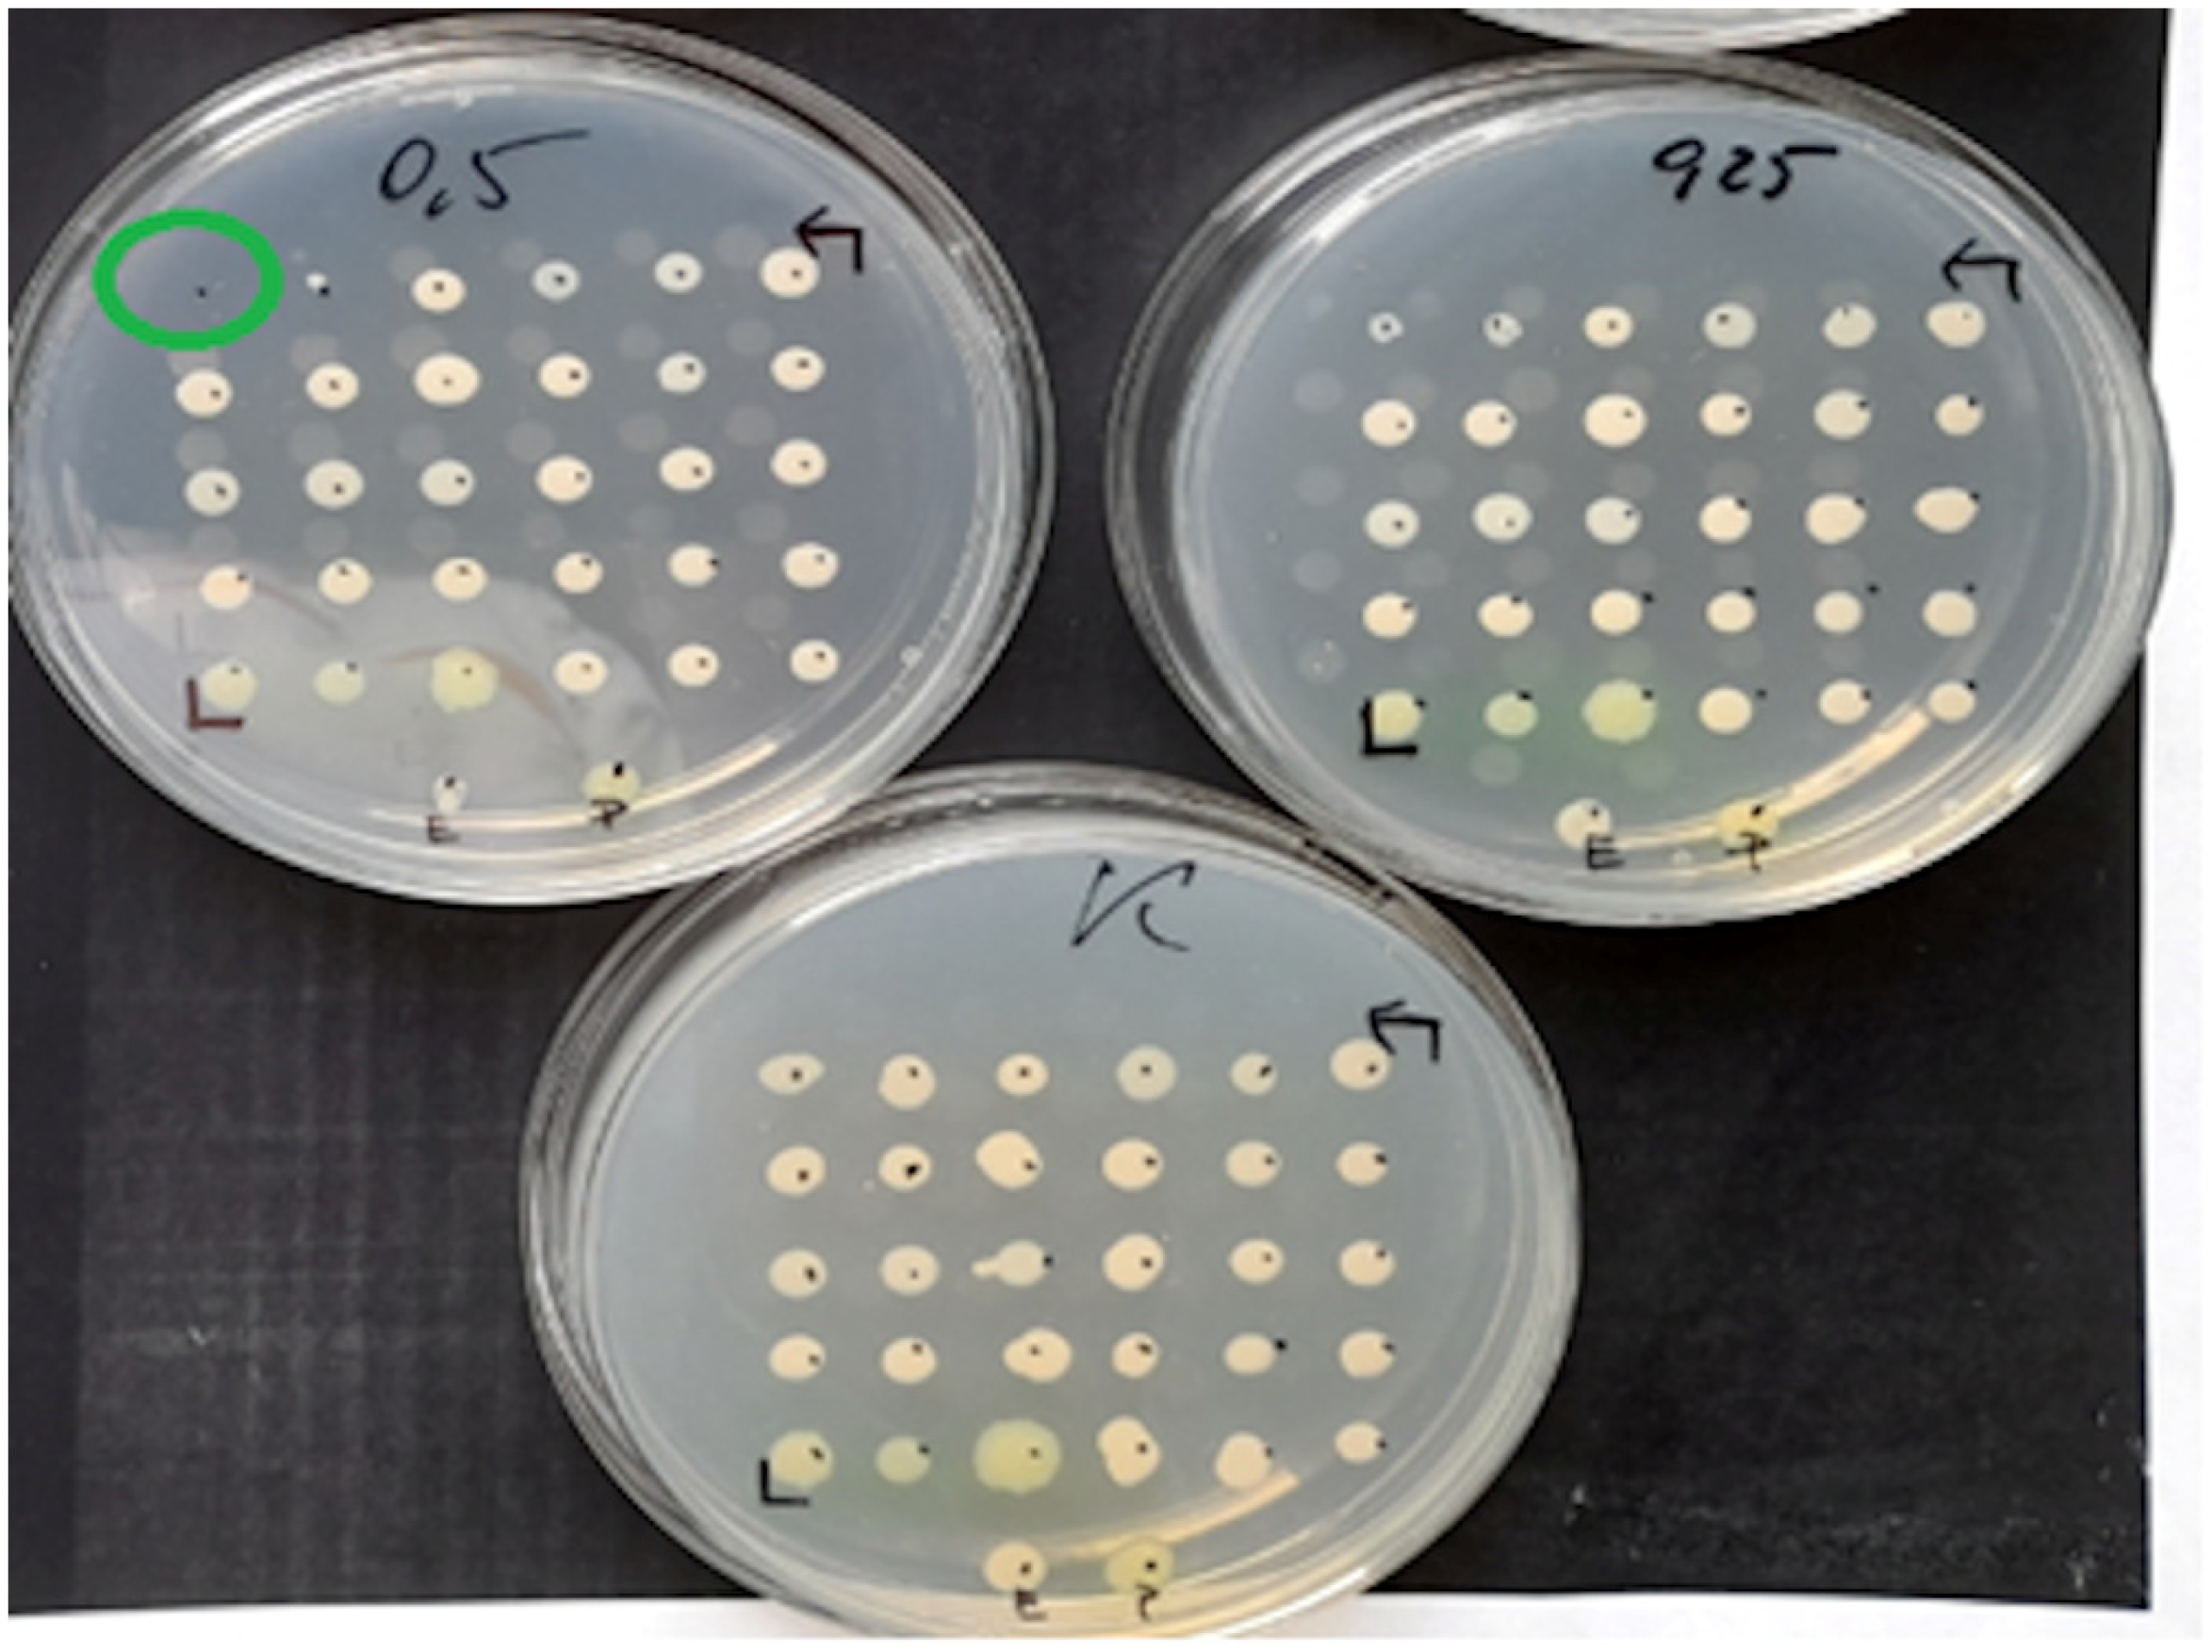
Pathogens 12 00700 g002
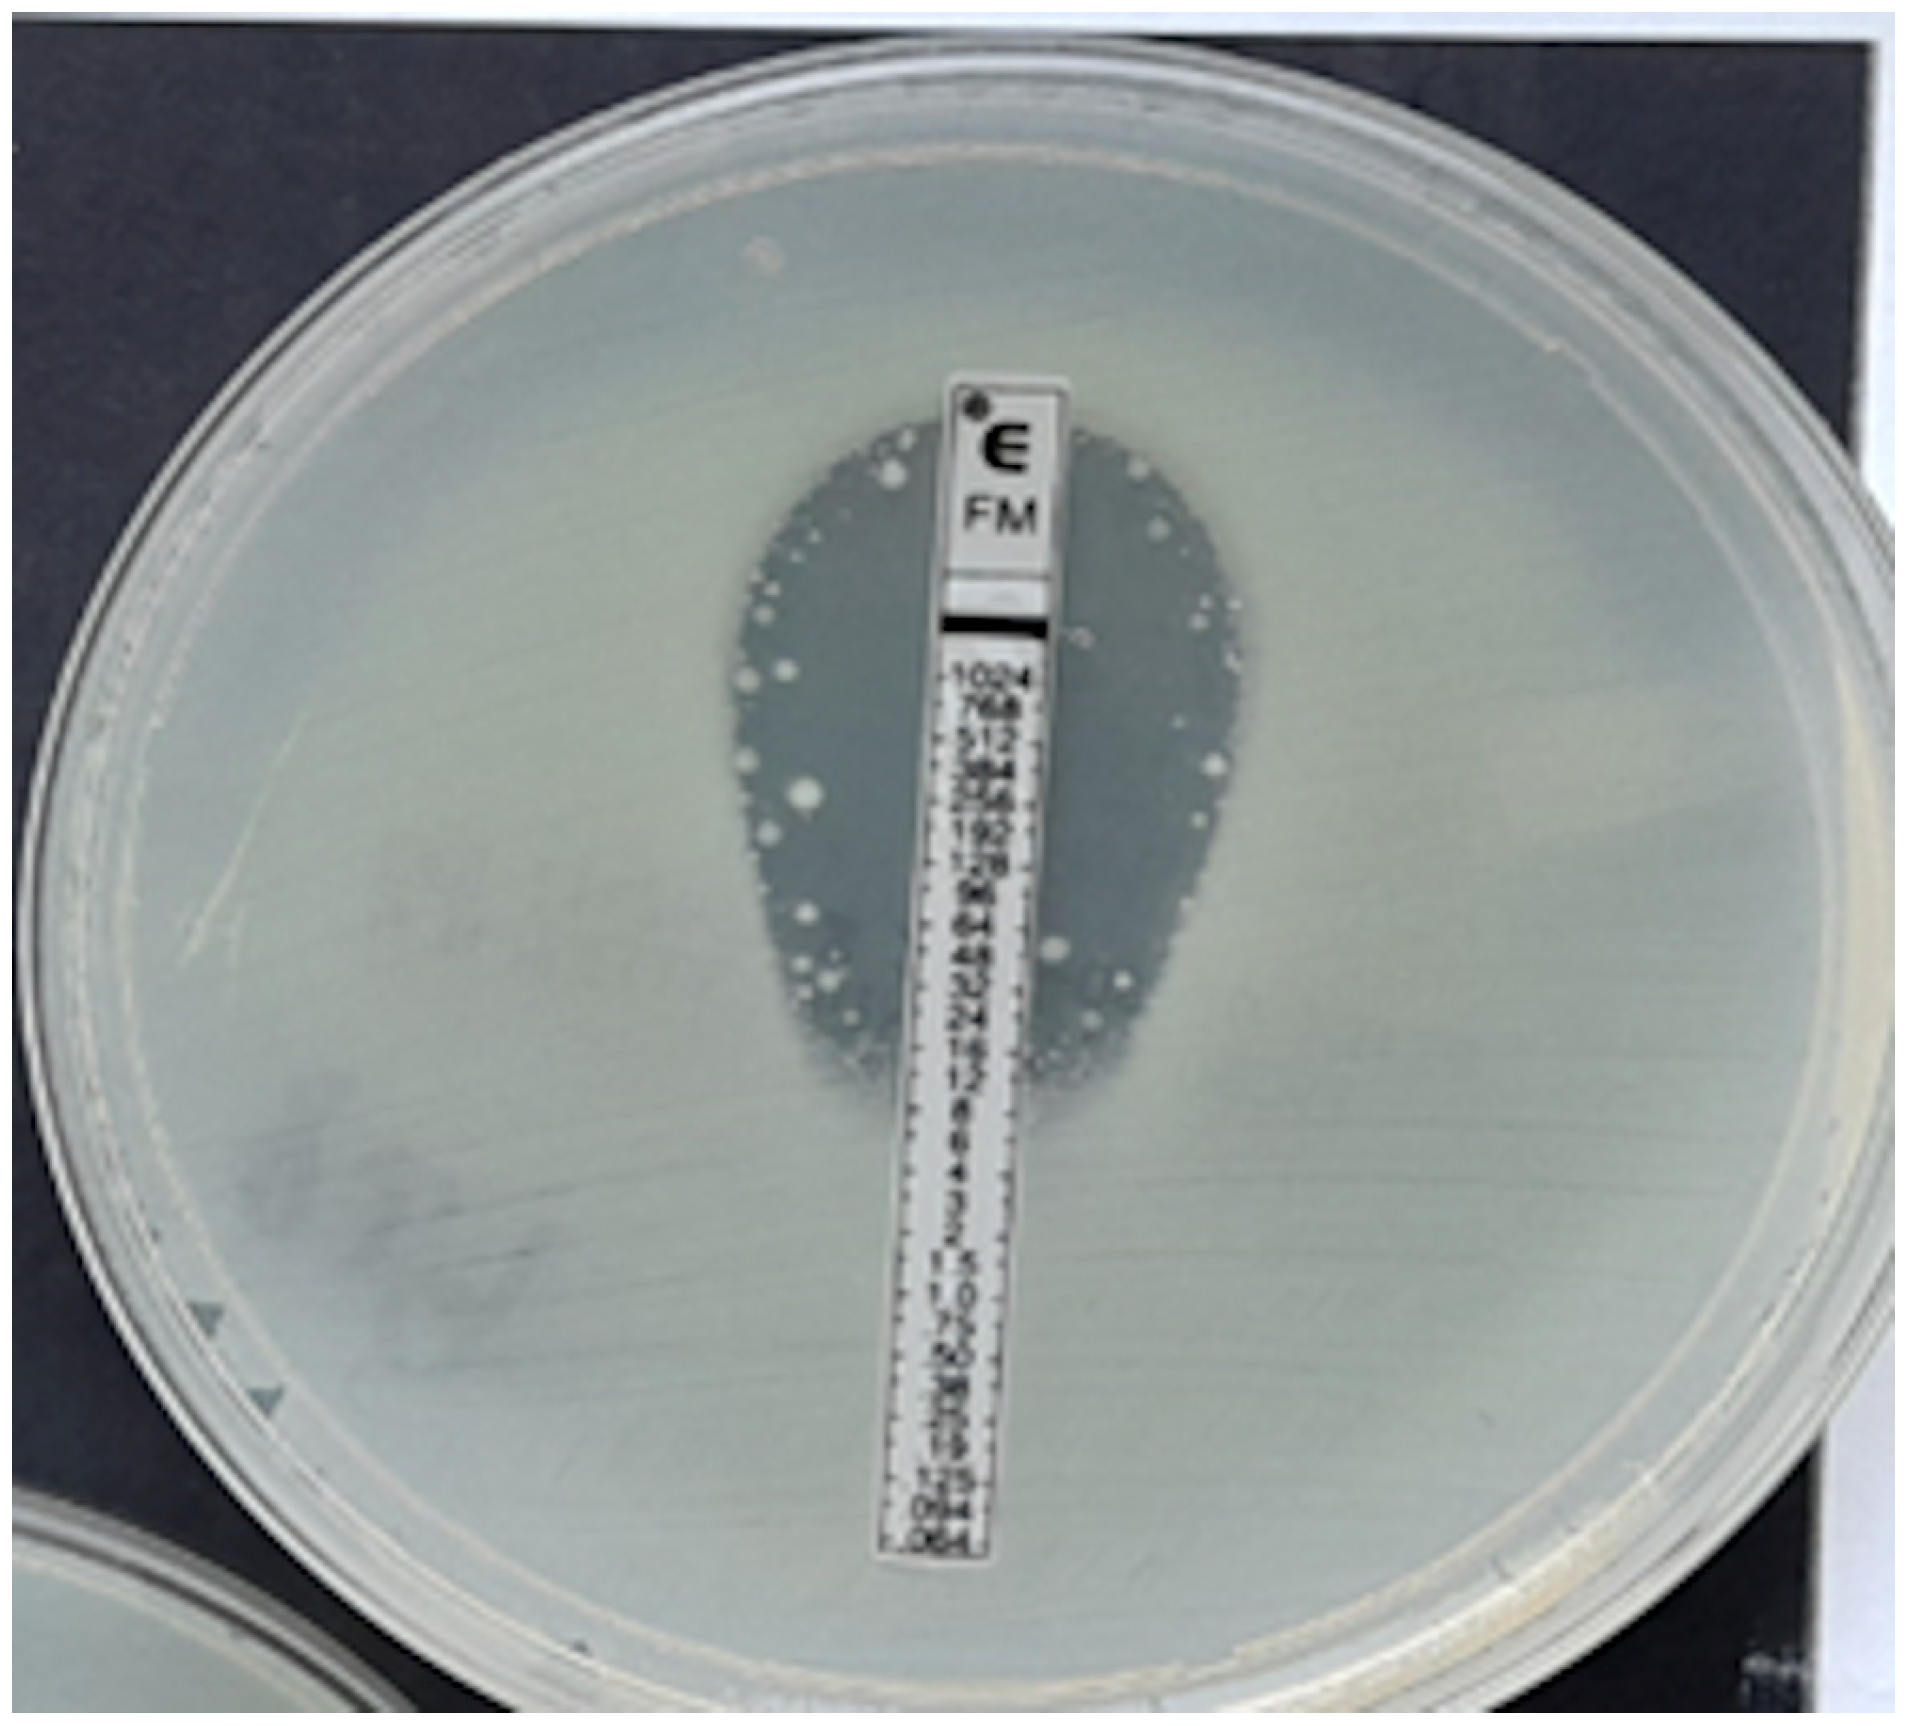
Pathogens 12 00700 g004

Reliability of E-Tests and the Phoenix Automated Method in Assessing Susceptibility to IV Fosfomycin—Comparative Studies Relative to the Reference Method
Abstract
1. Introduction
2. Materials and Methods
2.1. Agar Dilution Method—The Reference Method
2.2. Gradient Diffusion Method
2.3. Evaluation of Fosfomycin Susceptibility Using BD Phoenix Panels
- categorical agreement (CA)—agreement regarding clinical interpretation.
- major errors (ME) when the strain turns out to be sensitive using the ADM and resistant using the evaluated method.
- very major errors (VME) when the strain is determined as resistant in the ADM and susceptible in the method being evaluated.
- the ME and VME rates—calculated by dividing the number of errors by the total number of susceptible or resistant isolates, respectively, obtained by the reference method.
- differences in MIC values obtained by the E-test in relation to the ADM reference method. The occurrence of deviations of one, two, or more than two two-fold dilutions was analyzed; this analysis was performed only for the E-test vs. the ADM.
- essential agreement (EA)—agreement within plus or minus one two-fold dilution of the E-test with the reference method; this analysis was performed only for the E-test vs. the ADM.
3. Results
3.1. Assessment of Categorical Agreement (CA) and Error Rates for the E-Test and the Phoenix vs. the ADM
3.2. Evaluation of Agreement of MIC Values Obtained Using the E-Test and the Reference ADM
4. Discussion
5. Conclusions
Author Contributions
Funding
Data Availability Statement
Conflicts of Interest
References
- European Committee on Antimicrobial Susceptibility Testing. Breakpoint Tables for Interpretation of MICs and Zone Diameters. Version 13.0. Available online: https://www.eucast.org/fileadmin/src/media/PDFs/EUCAST_files/Breakpoint_tables/v_13.0_Breakpoint_Tables.pdf (accessed on 16 January 2023).
- CLSI. Performance Standards for Antimicrobial Susceptibility Testing, 32nd ed.; CLSI Supplement M100S; Clinical and Laboratory Standards Institute: Wayne, PA, USA, 2022; Available online: http://em100.edaptivedocs.net/Login.aspx (accessed on 15 December 2022).
- Kowalska-Krochmal, B.; Dudek-Wicher, R. The Minimum Inhibitory Concentration of Antibiotics: Methods, Interpretation, Clinical Relevance. Pathogens 2021, 10, 165. [Google Scholar] [CrossRef] [PubMed]
- Matuschek, E.; Åhman, J.; Webster, C.; Kahlmeter, G. Antimicrobial susceptibility testing of colistin–evaluation of seven commercial MIC products against standard broth microdilution for Escherichia coli, Klebsiella pneumoniae, Pseudomonas aeruginosa and Acinetobacter spp. Clin. Microbiol. Infect. 2018, 24, 865–870. [Google Scholar] [CrossRef] [PubMed]
- Karvanen, M.; Malmberg, C.; Lagerbäck, P.; Friberg, L.E.; Cars, O. Colistin is extensively lost during standard in vitro experimental conditions. Antimicrob. Agents Chemother. 2017, 61, e00857-17. [Google Scholar] [CrossRef] [PubMed]
- European Committee on Antimicrobial Susceptibility Testing. EUCAST Guidelines for Detection of Resistance Mechanisms and Specific Resistances of Clinical and/or Epidemiological Importance. 2017, Version 2.0. Available online: https://www.eucast.org/fileadmin/src/media/PDFs/EUCAST_files/Resistance_mechanisms/EUCAST_detection_of_resistance_mechanisms_170711.pdf (accessed on 23 April 2023).
- Fuchs, P.C.; Barry, A.L.; Brown, S.D. Susceptibility testing quality control studies with fosfomycin tromethamine. Eur. J. Clin. Microbiol. Infect. Dis. 1997, 16, 538–540. [Google Scholar] [CrossRef]
- Smith, E.C.; Brigman, H.V.; Anderson, J.C.; Emery, C.L.; Bias, T.E.; Bergen, P.J.; Landersdorfer, C.B.; Hirsch, E.B. Performance of four fosfomycin susceptibility testing methods against an international collection of clinical Pseudomonas aeruginosa isolates. J. Clin. Microbiol. 2020, 58, e1121-20. [Google Scholar] [CrossRef] [PubMed]
- Ballestero-Téllez, M.; Docobo-Pérez, F.; Rodríguez-Martínez, J.; Conejo, M.; Ramos-Guelfo, M.; Blázquez, J.; Rodríguez-Baño, J.; Pascual, A. Role of inoculum and mutant frequency on fosfomycin MIC discrepancies by agar dilution and broth microdilution methods in Enterobacteriaceae. Clin. Microbiol. Infect. 2017, 23, 325–331. [Google Scholar] [CrossRef]
- Zhanel, G.G.; Zhanel, M.A.; Karlowsky, J.A. Intravenous Fosfomycin: An Assessment of Its Potential for Use in the Treatment of Systemic Infections in Canada. Can. J. Infect. Dis. Med. Microbiol. 2019, 2018, 8912039. [Google Scholar] [CrossRef]
- Díez-Aguilar, M.; Cantón, R. New microbiological aspects of fosfomycin. Rev. Esp. Quimioter. 2019, 32, 8–18. [Google Scholar]
- Cao, Y.; Peng, Q.; Li, S.; Deng, Z.; Gao, J. The intriguing biology and chemistry of fosfomycin: The only marketed phosphonate antibiotic. RSC Adv. 2019, 9, 42204–42218. [Google Scholar] [CrossRef]
- Williams, P.C.M. Potential of fosfomycin in treating multidrug-resistant infections in children. J. Paediatr. Child Health 2020, 56, 864–872. [Google Scholar] [CrossRef]
- Dijkmans, A.C.; Zacarías, N.V.O.; Burggraaf, J.; Mouton, J.W.; Wilms, E.B.; van Nieuwkoop, C.; Touw, D.J.; Stevens, J.; Kamerling, I.M.C. Fosfomycin: Pharmacological, Clinical and Future Perspectives. Antibiotics 2017, 6, 24. [Google Scholar] [CrossRef] [PubMed]
- Stracquadanio, S.; Musso, N.; Costantino, A.; Lazzaro, L.M.; Stefani, S.; Bongiorno, D. Staphylococcus aureus Internalization in Osteoblast Cells: Mechanisms, Interactions and Biochemical Processes. What Did We Learn from Experimental Models? Pathogens 2021, 10, 239. [Google Scholar] [CrossRef] [PubMed]
- López-Montesinos, I.; Horcajada, J.P. Oral and intravenous fosfomycin in complicated urinary tract infections. Rev. Esp. Quimioter. 2019, 32, 37–44. [Google Scholar] [PubMed]
- European Committee on Antimicrobial Susceptibility Testing. Rationale Documents and Publications. Available online: https://www.eucast.org/publications-and-documents/rd (accessed on 8 May 2023).
- Zelmer, A.R.; Nelson, R.; Richter, K.; Atkins, G.J. Can intracellular Staphylococcus aureus in osteomyelitis be treated using current antibiotics? A systematic review and narrative synthesis. Bone Res. 2022, 10, 53. [Google Scholar] [CrossRef]
- Valour, F.; Trouillet-Assant, S.; Riffard, N.; Tasse, J.; Flammier, S.; Rasigade, J.P.; Chidiac, C.; Vandenesch, F.; Ferry, T.; Laurent, F. Antimicrobial activity against intraosteoblastic Staphylococcus aureus. Antimicrob. Agents Chemother. 2015, 59, 2029–2036. [Google Scholar] [CrossRef]
- European Committee for Antimicrobial Susceptibility Testing (EUCAST) of the European Society of Clinical Microbiology and Infectious Diseases (ESCMID). Determination of minimum inhibitory concentrations (MICs) of antibacterial agents by agar dilution. Clin. Microbiol. Infect. 2000, 6, 509–515. [Google Scholar] [CrossRef]
- AD Fosfomycin 0.25-256. Device for Fosfomycin Susceptibility Testing with the Agar Dilution Method. Liofilchem. Available online: http://www.liofilchem.net/login/pd/ifu/77061_IFU.pdf (accessed on 28 April 2020).
- Instruction of Use (IFU) ETEST® Fosfomycin (FO) (0.032–512 μg/mL); Customer Information Sheet No. 055177-01-2022-07–en; bioMerieux: Warsaw, Poland, 2022.
- European Committee on Antimicrobial Susceptibility Testing. Breakpoint Tables for Interpretation of MICs and Zone Diameters. Version 12.0. Available online: https://www.eucast.org/fileadmin/src/media/PDFs/EUCAST_files/Breakpoint_tables/v_12.0_Breakpoint_Tables.pdf (accessed on 1 January 2022).
- ISO. 2007 ISO/FDIS 20776 22:2007(E); Clinical Laboratory Testing and in Vitro Diagnostic Test Systems. Susceptibility Testing of Infection Agents and Evaluation of Performance of Antimicrobial Susceptibility Test Devices—Part 2, Evaluation of Performance of Antimicrobial Susceptibility Test Devices. ISO: Geneva, Switzerland, 2007.
- Hawkey, P.M.; Warren, R.E.; Livermore, D.M.; McNulty, C.A.M.; Enoch, D.A.; Otter, J.A.; Wilson, A.P.R. Treatment of infections caused by multidrug-resistant Gram-negative bacteria: Report of the British Society for Antimicrobial Chemotherapy/HealthcareInfection Society/British Infection Association Joint Working Party. J. Antimicrob. Chemother. 2018, 73, iii2–iii78. [Google Scholar] [CrossRef]
- Petrosillo, N.; Taglietti, F.; Granata, G. Treatment Options for Colistin Resistant Klebsiella pneumoniae: Present and Future. J. Clin. Med. 2019, 8, 934. [Google Scholar] [CrossRef]
- Bassetti, M.; Garau, J. Current and future perspectives in the treatment of multidrug-resistant Gram-negative infections. J. Antimicrob. Chemother. 2021, 76, iv23–iv37. [Google Scholar] [CrossRef]
- Paul, M.; Carrara, E.; Retamar, P.; Tängdén, T.; Bitterman, R.; Bonomo, R.A.; de Waele, J.; Daikos, G.L.; Akova, M.; Harbarth, S.; et al. European Society of Clinical Microbiology and Infectious Diseases (ESCMID) guidelines for the treatment of infections caused by multidrug-resistant Gram-negative bacilli (endorsed by European society of intensive care medicine). Clin. Microbiol. Infect. 2022, 28, 521–547. [Google Scholar] [CrossRef]
- Papp-Wallace, K.M.; Zeiser, E.T.; Becka, S.A.; Park, S.; Wilson, B.M.; Winkler, M.L.; D’Souza, R.; Singh, I.; Sutton, G.; Fouts, D.E.; et al. Ceftazidime-Avibactam in Combination with Fosfomycin: A Novel Therapeutic Strategy against Multidrug-Resistant Pseudomonas aeruginosa. J. Infect. Dis. 2019, 220, 666–676. [Google Scholar] [CrossRef] [PubMed]
- Albiero, J.; Mazucheli, J.; Barros, J.P.D.R.; Szczerepa, M.M.D.A.; Nishiyama, S.A.B.; CarraraMarroni, F.E.; Sy, S.; Fidler, M.; Sy, S.K.B.; Tognim, M.C.B. Pharmacodynamic attainment of the synergism of meropenem and fosfomycin combination against Pseudomonas aeruginosa producing metallo--lactamase. Antimicrob. Agents Chemother. 2019, 63, e00126-19. [Google Scholar] [CrossRef] [PubMed]
- Kowalska-Krochmal, B.; Mączyńska, B.; Rurańska-Smutnicka, D.; Secewicz, A.; Krochmal, G.; Bartelak, M.; Górzyńska, A.; Laufer, K.; Woronowicz, K.; Łubniewska, J.; et al. Assessment of the Susceptibility of Clinical Gram-Negative and Gram-Positive Bacterial Strains to Fosfomycin and Significance of This Antibiotic in Infection Treatment. Pathogens 2022, 11, 1441. [Google Scholar] [CrossRef] [PubMed]
- FDA. FDA Guidance for Industry: Class II Special Controls Guidance Document: Antimicrobial Susceptibility Test (AST) Systems; FDA: Silver Spring, MD, USA, 2009. [Google Scholar]
- Van den Bijllaardt, W.; Schijffelen, M.J.; Bosboom, R.W.; Cohen Stuart, J.; Diederen, B.; Kampinga, G.; Le, T.N.; Overdevest, I.; Stals, F.; Voorn, P.; et al. Susceptibility of ESBL Escherichia coli and Klebsiella pneumoniae to fosfomycin in the Netherlands and comparison of several testing methods including Etest, MIC test strip, Vitek2, Phoenix and disc diffusion. J. Antimicrob. Chemother. 2018, 73, 2380–2387. [Google Scholar] [CrossRef]
- Goer, A.; Blanchard, L.S.; Van Belkum, A.; Loftus, K.J.; Armstrong, T.P.; Gatermann, S.G.; Shortridge, D.; Olson, B.J.; Meece, J.K.; Fritsche, T.R.; et al. Multicenter Evaluation of the Novel ETEST Fosfomycin for Antimicrobial Susceptibility Testing of Enterobacterales, Enterococcus faecalis, and Staphylococcus Species. J. Clin. Microbiol. 2022, 60, e0002122. [Google Scholar] [CrossRef]
- Karlowsky, J.A.; Baxter, M.R.; Golden, A.R.; Adam, H.J.; Walkty, A.; Lagacé-Wiens, P.R.S.; Zhanel, G.G. Use of Fosfomycin Etest to Determine In Vitro Susceptibility of Clinical Isolates of Enterobacterales Other than Escherichia coli, Nonfermenting Gram-Negative Bacilli, and Gram-Positive Cocci. J. Clin. Microbiol. 2021, 59, e0163521. [Google Scholar] [CrossRef]
- Peradotto, M.; Bondi, A.; Bianco, G.; Iannaccone, M.; Barbui, A.M.; Costa, C.; Cavallo, R. Comparison of Three Different Commercial Methods for Fosfomycin Susceptibility Testing in Pseudomonas aeruginosa. Microb. Drug. Resist. 2022, 28, 911–915. [Google Scholar] [CrossRef]
- Van Mens, S.P.; ten Doesschate, T.; Kluytmans-van den Bergh, M.F.Q.; Mouton, J.W.; Rossen, J.W.A.; Verhulst, C.; Bonten, M.J.M.; Kluytmans, J.A.J.W. Fosfomycin ETEST for Enterobacteriaceae: Interobserver and interlaboratory agreement. Int. J. Antimicrob. Agents 2018, 52, 678–681. [Google Scholar] [CrossRef]
- Camarlinghi, G.; Parisio, E.M.; Antonelli, A.; Nardone, M.; Coppi, M.; Giani, T.; Mattei, R.; Rossolini, G.M. Discrepancies in fosfomycin susceptibility testing of KPC-producing Klebsiella pneumoniae with various commercial methods. Diagn. Microbiol. Infect. Dis. 2019, 93, 74–76. [Google Scholar] [CrossRef]
- Perdigao-Neto, L.V.; Oliveira, M.S.; Rizek, C.F.; Carrilho, M.; Costa, S.F.; Levin, A.S. Susceptibility of multiresistant gram-negative bacteria to fosfomycin and performance of different susceptibility testing methods. Antimicrob. Agents Chemother. 2014, 58, 1763–1767. [Google Scholar] [CrossRef]
- Liofilchem®-Fosfomycin MIC Test Strip Technical Sheet-MTS45-Rev.1/09 November 2017. Available online: http://www.liofilchem.net/login.area.mic/technical_sheets/MTS45.pdf (accessed on 15 February 2023).
- Souli, M.; Galani, I.; Boukovalas, S.; Gourgoulis, M.G.; Chryssouli, Z.; Kanellakopoulou, K.; Panagea, T.; Giamarellou, H. In Vitro Interactions of Antimicrobial Combinations with Fosfomycin against KPC-2-Producing Klebsiella pneumoniae and Protection of Resistance Development. Antimicrob. Agents Chemother. 2011, 55, 2395–2397. [Google Scholar] [CrossRef] [PubMed]
- Kaase, M.; Szabados, F.; Anders, A.; Gatermann, S.G. Fosfomycin susceptibility in carbapenem-Resistant Enterobacteriaceae from Germany. J. Clin. Microbiol. 2014, 52, 1893–1897. [Google Scholar] [CrossRef] [PubMed]
- Nilsson, A.I.; Berg, O.G.; Aspevall, O.; Kahlmeter, G.; Andersson, D.I. Biological Costs and Mechanisms of Fosfomycin Resistance in Escherichia coli. Antimicrob. Agents Chemother. 2003, 47, 2850–2858. [Google Scholar] [CrossRef] [PubMed]
- Elliott, Z.S.; Barry, K.E.; Co, H.L.; Stoesser, N.; Carroll, J.; Vegesana, K.; Kotay, S.; Sheppard, A.E.; Wailan, A.; Crook, D.W.; et al. The Role of fosA in Challenges with Fosfomycin Susceptibility Testing of Multispecies Klebsiella pneumoniae Carbapenemase-Producing Clinical Isolates. J. Clin. Microbiol. 2019, 57, e00634-19. [Google Scholar] [CrossRef]
- Doern, G.V.; Brecher, S.M. The Clinical Predictive Value (or Lack Thereof) of the Results of Antimicrobial Susceptibility Tests. J. Clin. Microbiol. 2011, 49, S11–S14. [Google Scholar] [CrossRef]

| Group of Bacterial Strains | MIC Breakpoints (mg/L) | |
|---|---|---|
| ≤S | >R | |
| Enterobacterales | 32 | 32 |
| P. aeruginosa | 128 | 128 |
| Staphylococcus spp. | 32 | 32 |
| Bacterial Strains | N | Susceptibility to IV Fosfomycin | |||||
|---|---|---|---|---|---|---|---|
| ADM | E-Test | Phoenix | |||||
| n | % | n | % | n | % | ||
| Overall (except Proteus) | 819 | 681 | 83.20 | 690 | 84.24 | 677 | 82.70 |
| Enterobacterales (except Proteus) | 505 | 391 | 77.42 | 421 | 83.36 | 415 | 82.17 |
| ESBL-producing Enterobacterales | 139 | 105 | 75.53 | 117 | 84.17 | 107 | 77.00 |
| CPE-producing Enterobacterales | 60 | 28 | 46.70 | 41 | 68.40 | 37 | 61.70 |
| Klebsiella spp. | 250 | 164 | 66.00 | 192 | 76.80 | 179 | 71.60 |
| E. coli | 181 | 170 | 93.92 | 168 | 92.80 | 170 | 93.92 |
| Enterobacter spp. | 47 | 34 | 72.30 | 37 | 78.70 | 40 | 85.10 |
| Proteus spp. | 41 | 34 | 82.90 | No assessment | 36 | 87.80 | |
| Pseudomonas spp. | 153 | 141 | 90.80 | 123 | 80.40 | 115 | 75.20 |
| MBL-producing Pseudomonas | 21 | 18 | 85.70 | 15 | 71.40 | 15 | 71.40 |
| Staphylococcus spp. | 161 | 146 | 90.70 | 146 | 90.70 | 147 | 91.3 |
| Staphylococcus aureus | 104 | 103 | 99.00 | 103 | 99.00 | 103 | 99.00 |
| Staphylococcus CNS | 57 | 43 | 75.40 | 43 | 75.40 | 44 | 77.20 |
| E-Test | Phoenix | |
|---|---|---|
| Klebsiella spp. n = 250 | ||
| CA | 84.00% (210/250) | 79.92% (199/250) |
| ME | 3.66% (6/164) | 10.43% (17/164) |
| VME | 39.53% (34/86) | 38.37% (33/86) |
| E. coli n=181 | ||
| CA | 96.68% (175/181) | 98.89% (179/181) |
| ME | 2.35% (4/170) | 0.59% (1/170) |
| VME | 18.18% (2/11) | 9.09% (1/11) |
| Enterobacter spp. n = 47 | ||
| CA | 89.36% (42/47) | 82.97% (39/47) |
| ME | 2.94% (1/34) | 2.94% (1/34) |
| VME | 30.77% (4/13) | 53.83% (7/13) |
| Proteus spp. n = 41 | ||
| CA | No assessment | 95.12% (39/41) |
| ME | No assessment | 0% (0/34) |
| VME | No assessment | 28.57% (2/7) |
| S. aureus n = 104 | ||
| CA | 100% (104/104) | 100% (104/104) |
| ME | 0% (0/103) | 0% (0/103) |
| VME | 0% (0/1) | 0% (0/1) |
| CNS n = 57 | ||
| CA | 89.47% (51/57) | 84.21% (48/57) |
| ME | 6.98% (3/43) | 9.3% (4/43) |
| VME | 21.43% (3/14) | 35.71% (5/14) |
| Bacterial Strains | Essential Agreement (EA) (%) | Same (%) | ±1 Two-Fold Dilution (%) | At Least ±2 Two-Fold Dilutions (%) |
|---|---|---|---|---|
| Overall | 75 | 33 | 42 | 25 |
| Enterobacterales | 75 | 30 | 45 | 25 |
| ESBL-producing Enterobacterales | 73 | 25 | 48 | 27 |
| Carbapenemase-producing Enterobacterales | 62 | 22 | 40 | 38 |
| Klebsiella spp. | 71 | 24 | 46 | 29 |
| E. coli | 78 | 35 | 44 | 22 |
| Enterobacter spp. | 79 | 32 | 47 | 21 |
| Pseudomonas spp. | 76 | 30 | 46 | 24 |
| MBL-producing Pseudomonas | 81 | 48 | 33 | 19 |
| S. aureus | 70 | 45 | 25 | 30 |
| CNS | 84 | 47 | 37 | 16 |
Disclaimer/Publisher’s Note: The statements, opinions and data contained in all publications are solely those of the individual author(s) and contributor(s) and not of MDPI and/or the editor(s). MDPI and/or the editor(s) disclaim responsibility for any injury to people or property resulting from any ideas, methods, instructions or products referred to in the content. |
© 2023 by the authors. Licensee MDPI, Basel, Switzerland. This article is an open access article distributed under the terms and conditions of the Creative Commons Attribution (CC BY) license (https://creativecommons.org/licenses/by/4.0/).
Share and Cite
Kowalska-Krochmal, B.; Mączyńska, B.; Smutnicka, D.; Secewicz, A.; Krochmal, G.; Laufer, K.; Dudek-Wicher, R. Reliability of E-Tests and the Phoenix Automated Method in Assessing Susceptibility to IV Fosfomycin—Comparative Studies Relative to the Reference Method. Pathogens 2023, 12, 700. https://doi.org/10.3390/pathogens12050700
Kowalska-Krochmal B, Mączyńska B, Smutnicka D, Secewicz A, Krochmal G, Laufer K, Dudek-Wicher R. Reliability of E-Tests and the Phoenix Automated Method in Assessing Susceptibility to IV Fosfomycin—Comparative Studies Relative to the Reference Method. Pathogens. 2023; 12(5):700. https://doi.org/10.3390/pathogens12050700
Chicago/Turabian StyleKowalska-Krochmal, Beata, Beata Mączyńska, Danuta Smutnicka, Anna Secewicz, Grzegorz Krochmal, Klaudyna Laufer, and Ruth Dudek-Wicher. 2023. "Reliability of E-Tests and the Phoenix Automated Method in Assessing Susceptibility to IV Fosfomycin—Comparative Studies Relative to the Reference Method" Pathogens 12, no. 5: 700. https://doi.org/10.3390/pathogens12050700
APA StyleKowalska-Krochmal, B., Mączyńska, B., Smutnicka, D., Secewicz, A., Krochmal, G., Laufer, K., & Dudek-Wicher, R. (2023). Reliability of E-Tests and the Phoenix Automated Method in Assessing Susceptibility to IV Fosfomycin—Comparative Studies Relative to the Reference Method. Pathogens, 12(5), 700. https://doi.org/10.3390/pathogens12050700

